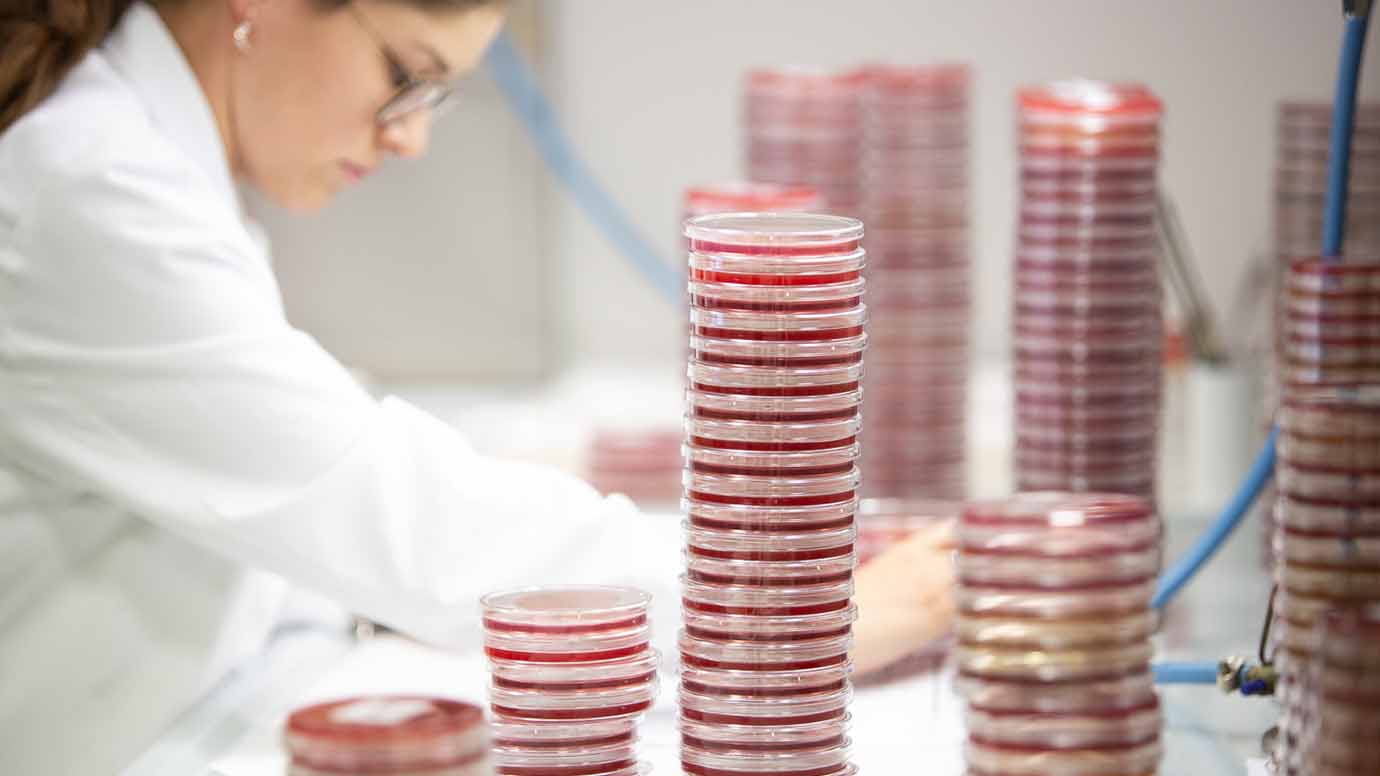

Per l’attività didattica si hanno a disposizione oltre 100 aule per un totale di circa 6.800 posti* a cui si sommano circa 300 posti in aule dedicate a laboratorio.
Data la vasta offerta formativa della Sede, l’attività didattica viene svolta presso gli Istituti Biologici, il Polo universitario "Giovanni XXIII", la Facoltà di Economia e la Fondazione Policlinico Universitario Agostino Gemelli IRCCS.
Aule e laboratori nel Campus di Roma

Facoltà di Economia: spazio di studio, incontro e ricreazione per gli studenti

Laboratori di Farmacia all'interno degli Istituti Biologici (Facoltà di Medicina e Chirurgia)

Nuovi Laboratori di Farmacia all'interno degli Istituti Biologici (Facoltà di Medicina e Chirurgia)

Aula "Agostino Gemelli" negli Istituti Biologici

Aula 202 della Facoltà di Economia nel Campus di Roma

Laboratorio nella Facoltà di Medicina e Chirurgia
Laboratorio della Facoltà di Medicina e Chirurgia

Aula della Facoltà di Economia nel Campus di Roma

Aula della Facoltà di Economia nel Campus di Roma
Laboratori / Aule di Microscopia
| AULA | PIANO | MONITOR | VIDEO | POSTI | LETTORE BADGE |
|---|---|---|---|---|---|
| Lab. Microscopia 1 | 1° | 2 | 32 | 1 | |
| Lab. Microscopia 2 | 1° | 2 | 32 | 1 | |
| Lab. Informatica | 0 | 24 | 1 | ||
| Lab. Linguistico | 0 | 24 | 1 |
| AULA | PIANO | MONITOR | POSTI | MICROSCOPI |
|---|---|---|---|---|
| Golgi | 1° | 2 | 33 | 33 |
| S. Giovanni di Dio | 1° | 2 | 30 | 30 |
| Morgagni | 1° | 2 | 30 | 30 |
| Pasteur | 1° | 2 | 25 | 25 |
| Spallanzani | 1° | 2 | 28 | 28 |
| Lab. Farmacia 1 | 3° | 24 | 24 | |
| Lab. Farmacia 2 | 3° | 16 | 16 |
Laboratori e la didattica dual-mode nelle aule di microscopia
Istituti Biologici
| AULA | PIANO | MONITOR | VIDEO | POSTI | LETTORE BADGE |
|---|---|---|---|---|---|
| San Luca | -1 | 2 | 1 | 226 | 3 |
| San Camillo | -1 | 2 | 1 | 224 | 3 |
| Moscati | 0 | 2 | 1 | 226 | 3 |
| Necchi | 0 | 2 | 1 | 220 | 3 |
| Gemelli | 1° | 4 | 1 | 450 | 3 |
| 139 | -1 | 1 | 1 | 24 | |
| 113 | -1 | 2 | 1 | 60 | |
| 141 | -1 | 1 | 54 | 1 | |
| 449 | 2° | 1 | 24 | 1 | |
| 413 | 2° | 1 | 30 | 1 | |
| 428 | 2° | 1 | 30 | ||
| C | 2° | 1 | 21 | 1 | |
| D | 3° | 1 | 29 |
Polo "Giovanni XXIII"
| AULA | PIANO | MONITOR | VIDEO | POSTI | LETTORE BADGE |
|---|---|---|---|---|---|
| Aula 1 | 0 | 2 | 1 | 138 | 1 |
| Aula 2 | 0 | 2 | 1 | 92 | 1 |
| Aula 3 | 1° | 1 | 60 | 1 | |
| Aula 4 | 1° | 1 | 60 | 1 | |
| Aula 5 | 1° | 2 | 1 | 150 | 1 |
| Aula 6 | 1° | 2 | 1 | 150 | 1 |
| Aula 7 | 1° | 1 | 85 | 1 | |
| Lazzati | 1° | 1 | 277 | 1 | |
| Bausola | 1° | 4 | 1 | 280 | 1 |
| Franceschini | 0 | 4 | 1 | 280 | 1 |
| Lab. Microscopia 1 | 1° | 2 | 32 | 1 | |
| Lab. Microscopia 2 | 1° | 2 | 32 | 1 | |
| Lab. Informatica | 0 | 50 | 1 | ||
| Lab. Linguistico | 0 | 50 | 1 |
Edificio della Facoltà di Economia
| AULA | PIANO | MONITOR | VIDEO | POSTI | LETTORE BADGE |
| 12 | 1° | 40 | |||
| 13 | 1° | 30 | |||
| 14 | 1° | 40 | |||
| 15 | 1° | 40 | |||
| 16 | 1° | 40 | |||
| 20 | 1° | 60 | |||
| 101 | 1° | 1 | 1 | 60 | 1 |
| 101 bis | 1° | 1 | 1 | 26 | 1 |
| 102 | 1° | 1 | 1 | 88 | 1 |
| 103 | 1° | 1 | 32 | ||
| 104 | 1° | 1 | 54 | ||
| 105 | 1° | 1 | 45 | ||
| 106 | 1° | 1 | 54 | ||
| 108 | 1° | 90 | |||
| 109 | 1° | 90 | |||
| 201 | 2° | 1 | 100 | ||
| 202 | 2° | 1 | 120 | 1 | |
| 202 bis | 2° | 1 | 100 | 1 | |
| 204 | 2° | 1 | 1 | 112 | 1 |
| 205 | 2° | 1 | 24 | 1 | |
| 206 | 2° | 1 | 27 | ||
| 207 | 2° | 1 | 27 | ||
| 208 | 2° | 1 | 27 |
Fondazione Policlinico Universitario Agostino Gemelli IRCCS
| AULA | PIANO | MONITOR | VIDEO | POSTI | LETTORE BADGE |
|---|---|---|---|---|---|
| 1 - Ala Q | 1° | 1 | 182 | 1 | |
| 3 - Ala Q | 2° | 1 | 1 | 96 | 1 |
| 4 - Ala Q | 2° | 1 | 1 | 64 | 1 |
| 402 | 4° | 1 | 26 | ||
| Brasca | 4° | 1 | 428 | 1 | |
| Vito | 4° | 1 | 450 | 1 | |
| 503 | 5° | 1 | 1 | 19 | |
| 504 | 5° | 1 | 1 | 16 | |
| 505 | 5° | 1 | 12 | ||
| 506 | 5° | 1 | 14 | ||
| 509 | 5° | 1 | 16 | ||
| 527 | 5° | 1 | 16 | ||
| 528 | 5° | 1 | 20 | ||
| 601 | 6° | 1 | 12 | ||
| 602 | 6° | 1 | 12 | ||
| 603 | 6° | 1 | 12 | ||
| 604 | 6° | 1 | 12 | ||
| 605 | 6° | 1 | 12 | ||
| 606 | 6° | 1 | 12 | ||
| 607 | 6° | 1 | 24 | ||
| 615 | 6° | 1 | 70 | 1 | |
| 616 | 6° | 1 | 70 | 1 | |
| 617 | 6° | 1 | 210 | 1 | |
| 702 | 7° | 1 | 32 | ||
| 703 | 7° | 1 | 46 | ||
| 705 | 7° | 1 | 18 | ||
| 706 | 7° | 1 | 60 | 1 | |
| 708 | 7° | 1 | 16 | ||
| 715 | 7° | 1 | 70 | 1 | |
| 716 | 7° | 1 | 70 | 1 | |
| 802 | 8° | 1 | 16 | ||
| 803 | 8° | 1 | 16 | ||
| 804 | 8° | 1 | 16 | ||
| 805 | 8° | 1 | 30 | ||
| 805 bis | 8° | 1 | 16 | ||
| 806 | 8° | 1 | 30 | ||
| 807 | 8° | 1 | 16 | ||
| 808 | 8° | 1 | 16 | ||
| 809 | 8° | 1 | 16 | ||
| 810 | 8° | 1 | 1 | 280 | 1 |
| 994 | 9° | 1 | 1 | 72 | 1 |
Biblioteche e Aree studio
| UBICAZIONE | PIANO | PC | POSTI | FOTOCOPIATRICE |
|---|---|---|---|---|
| BIBLIOTECHE | ||||
| Policlinico A. Gemelli | 4°- 5°- 6° | 40 | 232 | 1 |
| Polo "Giovanni XXIII" | 1°- 2° | 6 | 182 | 1 |
| Istituti Biologici | 0 - 1° | 12 | 229 | 1 |
| UBICAZIONE | PIANO | PC | POSTI | FOTOCOPIATRICE |
|---|---|---|---|---|
| AREE STUDIO | ||||
| Policlinico A. Gemelli | 5° | 40 | ||
| Polo "Giovanni XXIII" | 1° | 200 | ||
| Istituti Biologici | 1°- 2° | 50 | ||
| Facoltà di Economia | 1°- 2° | 30 | ||
| Spazi esterni | 38 |


